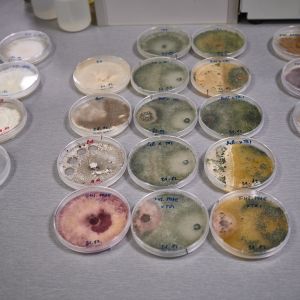

Ohlédnutí za Dnem otevřených dveří 2022

Den otevřených dveří je na Zemědělské fakultě již mnohaletou tradicí a ani tento rok nebyl výjimkou. 21. ledna 2022 jsme přivítali všechny zájemce o studium v pavilonu ZR, kde bylo informační centrum. Zde podávali studenti jednotlivých kateder informace o oborech a možnostech, které jejich katedry nabízejí. Vyjma získání podrobných informací k přihláškám a nabízeným studijním programům, si studenti mohli prohlédnout zázemí fakulty, laboratoře i špičkovou techniku, kterou fakulta disponuje, např. robotickou ruku pro automatizované dojení skotu, drony nebo geodetické a meteorologické přístroje, stejně jako ukázky umělé inteligence. Vědu a výzkum reprezentovaly chemické pokusy, ukázky vybraných polních plodin, vývoj hmyzu v čase, ukázky měření fotosyntézy či multimediální učebna botaniky.
Současní studenti těm budoucím přiblížili nejen univerzitní studentský život. Poskytli jim také podrobné informace o nabízených studijních programech, náplni studia, požadavcích pro přijetí, uplatnění absolventů v praxi, možnostech vyjet na stáž do zahraničí i o novinkách, které se na nový akademický rok 2022/2023 připravují.
Se širokou nabídkou studijních programů se můžete seznámit také na www.zf.jcu.cz. A my se budeme těšit, že někteří z vás, si tak jako v předchozích letech, vyberou ke studiu právě naši fakultu.
Foto: Miloš Vatrt